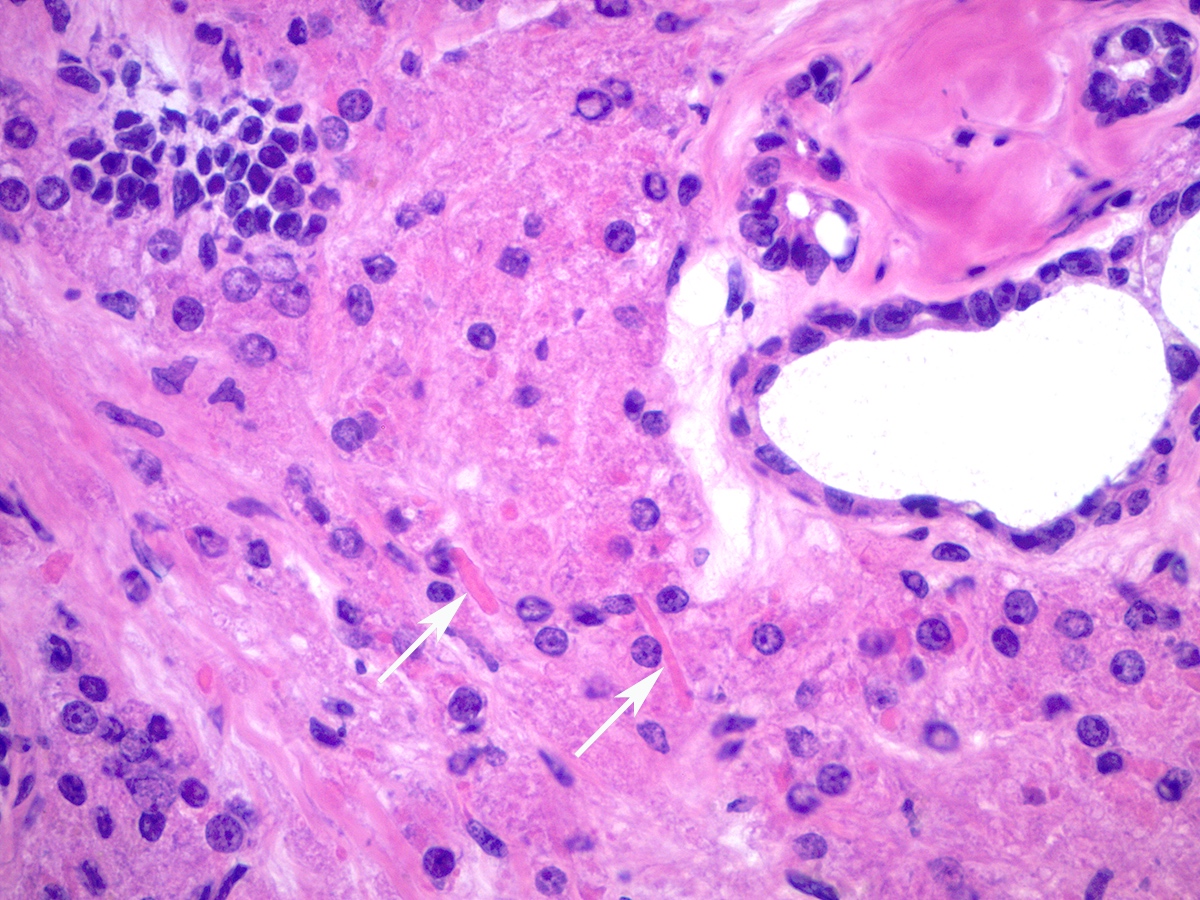

Table of Contents
Definition / general | Essential features | Terminology | ICD coding | Epidemiology | Sites | Pathophysiology | Etiology | Clinical features | Diagnosis | Laboratory | Radiology description | Radiology images | Prognostic factors | Case reports | Treatment | Gross description | Gross images | Frozen section description | Frozen section images | Microscopic (histologic) description | Microscopic (histologic) images | Positive stains | Negative stains | Molecular / cytogenetics description | Sample pathology report | Differential diagnosis | Board review style question #1 | Board review style answer #1 | Board review style question #2 | Board review style answer #2Cite this page: Buza N. Sertoli-Leydig cell tumor. PathologyOutlines.com website. https://www.pathologyoutlines.com/topic/ovarytumorsertolileydig.html. Accessed April 25th, 2024.
Definition / general
- Rare ovarian tumor composed of sex cord (Sertoli cells) and stromal (Leydig cells) elements, accounting for < 0.5% of all ovarian neoplasms
Essential features
- Rare ovarian tumor composed of sex cord (Sertoli cells) and stromal (Leydig cells) elements
- May occur sporadically or in patients with DICER1 syndrome
- 3 molecular subtypes (Am J Surg Pathol 2019;43:628):
- DICER1 mutant: younger age, moderately / poorly differentiated, retiform or heterologous elements
- FOXL2 c.402C>G (p.Cys134Trp) mutant: postmenopausal patients, moderately / poorly differentiated, no retiform or heterologous elements
- DICER1 / FOXL2 wildtype: intermediate age, no retiform or heterologous elements, including all well differentiated tumors
- Express general sex cord markers (inhibin, calretinin, SF1, FOXL2 and CD56); CK7 and EMA immunostains are negative
- Behavior correlates with tumor grade and histologic subtype
Terminology
- Sertoli-Leydig cell tumor
- Well differentiated
- Moderately differentiated / intermediate grade
- Poorly differentiated
- Sertoli-Leydig cell tumor with heterologous elements
- Sertoli-Leydig cell tumor, retiform variant
- Histologic grade and subtype correlates with clinical behavior (see Prognostic factors)
ICD coding
- ICD-O:
- 8631/1 - Sertoli-Leydig cell tumor, NOS
- ICD-11:
- XH0UP7 - Sertoli-Leydig cell tumor of intermediate differentiation
- XH6FQ9 - Sertoli-Leydig cell tumor, NOS
- XH8U56 - Sertoli-Leydig cell tumor, intermediate differentiation, with heterologous elements
- XH6XB6 - Sertoli-Leydig cell tumor, retiform
- XH3PN1 - Sertoli-Leydig cell tumor, retiform, with heterologous elements
Epidemiology
- Rare, accounting for < 0.5% of all ovarian neoplasms and 1 - 2% of pediatric ovarian cancers
- Most common in young patients with a mean age of 25 years (Am J Surg Pathol 1985;9:543)
- May also present after menopause (Eur J Gynaecol Oncol 2017;38:214)
- Tumors with a retiform pattern or germline DICER1 mutation occur at a younger age (Gynecol Oncol 2017;147:521)
- Nearly all pediatric Sertoli-Leydig cell tumors are moderately or poorly differentiated, are DICER1 syndrome associated and often show a retiform pattern or heterologous elements
Sites
- Ovary
Pathophysiology
- May occur sporadically or in patients with DICER1 syndrome (OMIM: Pleuropulmonary Blastoma; PPB [Accessed 16 August 2021])
- Rare tumor predisposition syndrome caused by germline mutations in DICER1, a gene encoding the RNase III enzyme in the microRNA maturation pathway (N Engl J Med 2012;366:234, Br J Cancer 2013;109:2744)
- Other tumors and disorders associated with DICER1 syndrome include pleuropulmonary blastoma, cystic nephroma, multinodular goiter and botryoid embryonal rhabdomyosarcoma, among others (Nat Rev Cancer 2014;14:662)
- Germline mutation is generally a truncating mutation; may occur anywhere in the gene
- Second hit somatic mutation is a focused hotspot missense mutation affecting the RNase IIIb domain of DICER1 (Histopathology 2016;69:903)
- Sporadic Sertoli-Leydig cell tumors (moderately and poorly differentiated) harbor somatic mutations at the same hotspot of DICER1 gene (Am J Surg Pathol 2017;41:1178)
- Somatic hotspot DICER1 mutations are present in approximately half of all cases (range: 15 - 97%), 61 - 69% of which also have germline DICER1 mutations (Am J Surg Pathol 2017;41:1178, Gynecol Oncol 2017;147:521, Histopathology 2016;68:279)
Etiology
- May occur sporadically or in patients with DICER1 syndrome (see Pathophysiology) (OMIM: Pleuropulmonary Blastoma; PPB [Accessed 16 August 2021])
Clinical features
- Clinical presentation may include pelvic pain or a pelvic mass, rarely with ascites and tumor rupture
- Androgenic hormonal symptoms (virilization) are common and present in approximately 50% of patients; they include hirsutism, clitoromegaly, breast atrophy and menstrual irregularity or amenorrhea (Am J Surg Pathol 1985;9:543)
- Estrogenic hormonal manifestations are rare
Diagnosis
- May be suspected clinically in a young patient presenting with a combination of virilization, elevated testosterone levels and ovarian / pelvic mass on imaging studies
- Clinical presentation often overlaps with other, more common entities, as nearly half of patients with Sertoli-Leydig cell tumors lack the characteristic androgenic symptoms and may be older (peri or postmenopausal, expanding the clinical differential diagnosis) (Eur J Gynaecol Oncol 2017;38:214)
- Intraoperative frozen section evaluation is helpful to confirm the clinical suspicion and guide the surgical management
Laboratory
- May have elevated testosterone (Eur J Gynaecol Oncol 2017;38:214)
Radiology description
- Ultrasound, pelvic CT or MRI can show a solid or solid and cystic adnexal mass
Prognostic factors
- Behavior correlates with tumor grade and histologic subtype
- Well differentiated Sertoli-Leydig cell tumors are essentially benign
- Approximately 10% of moderately differentiated and 13 - 59% of poorly differentiated tumors have malignant behavior (Gynecol Oncol 2012;125:673, Gynecol Oncol 2012;127:384, J Obstet Gynaecol Res 2013;39:305)
- Heterologous elements, retiform pattern, tumor rupture and spread outside the ovary (stage II or higher tumor stage) are adverse prognostic factors (J Obstet Gynaecol Res 2013;39:305, Gynecol Oncol 2012;125:673)
- Patients with germline DICER1 mutations have a favorable prognosis compared with those with somatic DICER1 mutations only (Gynecol Oncol 2017;147:521)
Case reports
- 15 year old girl with Sertoli-Leydig cell tumor and DICER1 mutation (Case Rep Obstet Gynecol 2018;2018:7927362)
- 20 and 21 year old sisters with Sertoli-Leydig cell tumor and DICER1 syndrome (Medicine (Baltimore) 2020;99:e20806)
- 68 year old woman with ovarian Sertoli-Leydig cell tumor with heterologous hepatocytes and a hepatocellular carcinomatous element (Int J Gynecol Pathol 2019;38:247)
- 3 cases of bilateral ovarian Sertoli-Leydig cell tumors in patients with DICER1 syndrome (Histopathology 2020;77:223)
- 9 of 16 cases of familial multinodular goiter and Sertoli-Leydig cell tumors are associated with a large intragenic in frame DICER1 deletion (Eur J Endocrinol 2018;178:K11)
Treatment
- Conservative fertility sparing surgery (unilateral salpingo-oophorectomy) and staging procedure (with or without lymphadenectomy) is usually performed in young patients with stage I tumors (Gynecol Oncol 2012;125:673, Gynecol Oncol 2012;127:384, J Obstet Gynaecol Res 2013;39:305)
- Older patients who do not wish to preserve fertility typically undergo bilateral salpingo-oophorectomy, total hysterectomy and complete surgical staging
- Platinum based adjuvant chemotherapy has also been reported in patients with moderately and poorly differentiated tumors, heterologous mesenchymal elements, advanced stage or rupture (J Obstet Gynaecol Res 2013;39:305, Eur J Gynaecol Oncol 2017;38:214)
- Genetic counseling and germline DICER1 mutation testing is recommended (Am J Surg Pathol 2017;41:1178)
Gross description
- Almost always unilateral (Am J Surg Pathol 1985;9:543)
- Tumor size ranges widely from < 1 cm to 35 cm (mean 12 - 14 cm) (Am J Surg Pathol 1985;9:543)
- Cut surface is typically solid, tan-yellow
- Cystic component may also be seen, especially in tumors with heterologous elements or with a retiform morphologic pattern
- Poorly differentiated tumor may show grossly identifiable foci of necrosis
Frozen section description
- Most critical issue is differentiation from epithelial ovarian malignancies
- Unlike epithelial malignancies, Sertoli-Leydig cell tumor is almost always unilateral and typically occurs in younger patients
- Clinical history of hormonal (androgenic) symptoms is helpful and should be actively sought from the surgical team
- Key microscopic features on frozen section include admixture of Sertoli cell tubules or compressed cords with variable amount of Leydig cell clusters
- Intracytoplasmic Reinke crystals may be better preserved compared to formalin fixed paraffin embedded permanent sections
- Sertoli-Leydig cell tumor: fertility sparing surgery is typically performed in younger patients
- Epithelial ovarian malignancies: generally requires complete surgical staging and the role of fertility preserving surgery is more controversial (Hui: Atlas of Intraoperative Frozen Section Diagnosis in Gynecologic Pathology, 1st Edition, 2015, Mod Pathol 1999;12:933, J Obstet Gynaecol Res 2013;39:305, Gynecol Oncol 2012;125:673)
Frozen section images
Microscopic (histologic) description
- Difficulty of histologic diagnosis increases with tumor grade
- While Sertoli and Leydig components can be readily identified in well differentiated tumors, less differentiated tumors lack well formed Sertoli cell tubules and have fewer Leydig cells
- Well differentiated
- Open or compressed Sertoli cell tubules, admixed with clusters of Leydig cells in the intervening stroma
- Sertoli cells are low columnar to cuboidal with oval to round nuclei, which often show nuclear grooves and small nucleoli
- Leydig cells can be recognized by their round nuclei and abundant eosinophilic cytoplasm with characteristic Reinke crystals and lipofuscin pigment
- No significant atypia or mitotic activity
- Moderately differentiated
- Typically has a diffuse or lobulated architectural pattern and may show alternating hypo and hypercellularity on low magnification
- Sertoli cells form compressed tubules, cords or diffuse sheets and have hyperchromatic, oval or spindled nuclei with mild to moderate atypia and occasional mitotic figures (average 5 per 10 high power fields)
- Rare small clusters of Leydig cells are admixed with the Sertoli cell component
- Follicular differentiation may be seen in moderately and poorly differentiated tumors and may resemble juvenile granulosa cell tumor (Am J Surg Pathol 2021;45:59)
- Poorly differentiated
- Diffuse sheets of immature, sarcomatoid Sertoli cells with moderate to marked nuclear atypia and only rare foci of vague cord formation
- Increased mitotic activity, up to 20 mitoses per 10 high power fields
- Leydig cells are difficult to find; a few small clusters are typically located at the periphery of tumor nodules
- Sertoli-Leydig cell tumor with heterologous elements
- Heterologous (epithelial or mesenchymal) elements may be seen in approximately 20% of moderately or poorly differentiated tumors and in retiform Sertoli-Leydig cell tumor (Am J Surg Pathol 1985;9:543)
- Most common heterologous element is mucinous (intestinal or gastric type) epithelium, which may be benign, borderline or malignant (Cancer 1982;50:2448)
- Carcinoid tumor (trabecular or goblet cell) has also been described arising from heterologous mucinous epithelial elements (Cancer 1982;50:2448)
- Heterologous mesenchymal (cartilage or skeletal muscle) elements are less common (Cancer 1982;50:2465)
- Rare focal hepatocyte differentiation has also been reported and may be associated with increased serum AFP (Hum Pathol 1999;30:611)
- Sertoli-Leydig cell tumor, retiform variant
- Approximately 15% of Sertoli-Leydig cell tumors demonstrate focal or diffuse retiform pattern, forming anastomosing, slit-like, irregular spaces or multicystic, sieve-like or papillary architecture (Am J Surg Pathol 1985;9:543, Am J Surg Pathol 1983;7:755)
Microscopic (histologic) images
Positive stains
- General sex cord proteins, such as inhibin, calretinin, SF1, FOXL2, CD56, WT1 and CD99 (Am J Surg Pathol 1997;21:583, Arch Pathol Lab Med 2017;141:1052)
- Vimentin and pancytokeratin (Am J Surg Pathol 2007;31:592)
- MelanA / MART1 in Leydig cells (Am J Surg Pathol 2011;35:484)
- CK20 and CDX2 in heterologous intestinal type mucinous epithelium
- AFP, arginase and HepPar1 in hepatoid elements
- Reticulin histochemical staining may be helpful in differentiating Sertoli-Leydig cell tumor (completely absent or nested pattern) from fibromas and thecomas (individual pericellular reticulin network)
- Absence of reticulin staining is not specific for Sertoli-Leydig cell tumors, as adult granulosa cell tumors and epithelial ovarian tumors also show the same staining pattern (Int J Gynecol Pathol 2018;37:305)
Negative stains
- CK7 and EMA immunostains are negative; helpful in distinguishing Sertoli-Leydig cell tumors from ovarian epithelial tumors (Arch Pathol Lab Med 2017;141:1052)
- Reticulin is absent (highlights the individual pericellular reticulin network in ovarian fibromas / thecomas; also absent in adult granulosa cell tumors and epithelial ovarian tumors) (Int J Gynecol Pathol 2018;37:305)
Molecular / cytogenetics description
- 3 molecular subtypes (Am J Surg Pathol 2019;43:628):
- DICER1 mutant: younger age, moderately / poorly differentiated, retiform or heterologous elements
- FOXL2 c.402C>G (p.Cys134Trp) mutant: postmenopausal patients, moderately / poorly differentiated, no retiform or heterologous elements
- DICER1 / FOXL2 wildtype: intermediate age, no retiform or heterologous elements, including all well differentiated tumors
- Somatic hotspot DICER1 mutations are present in approximately half of all cases (range: 15 - 97%), 61 - 69% of which also have germline DICER1 mutations (Gynecol Oncol 2017;147:521, Am J Surg Pathol 2017;41:1178, Histopathology 2016;68:279, Mod Pathol 2015;28:1603)
- More recent study identified DICER1 mutations in all of their moderately and poorly differentiated tumors, whereas none of the well differentiated tumors had DICER1 mutations, raising the possibility that well differentiated Sertoli-Leydig cell tumors may represent a different pathogenetic entity (Am J Surg Pathol 2017;41:1178)
- FOXL2 mutation has been reported in up to 22% of ovarian Sertoli-Leydig cell tumors and is mutually exclusive with DICER1 mutations (Histopathology 2016;68:279, J Pathol 2010;221:147, Int J Gynecol Pathol 2018;37:305)
Sample pathology report
- Ovary and fallopian tube, right, salpingo-oophorectomy:
- Sertoli-Leydig cell tumor of the ovary, poorly differentiated, with heterologous elements (embryonal rhabdomyosarcoma) (see comment)
- Tumor size: 28 cm
- Tumor ruptured intraoperatively (see surgeon's operative report)
- Ovarian surface involvement: not definitely identified
- Fallopian tube: negative for tumor
- TNM stage (AJCC 8th edition): pT1c1 Nx, at least stage IC1
- Comment: Pelvic wash cytology is negative. Referral for genetic counseling is recommended.
Differential diagnosis
- Sertoli-Leydig cell tumor:
- Endometrioid adenocarcinoma, especially sertoliform variant (Mod Pathol 1999;12:933):
- Positive for CK7 and EMA and negative for sex cord markers (Arch Pathol Lab Med 2017;141:1052)
- Presence of squamous differentiation is helpful
- Adult granulosa cell tumor:
- Lacks Leydig cell component
- Majority of tumors have FOXL2 mutations (Histopathology 2016;68:279, J Pathol 2010;221:147, Int J Gynecol Pathol 2018;37:305)
- Fibroma:
- Lacks Leydig cell component
- Reticulin stain shows individual pericellular network (Int J Gynecol Pathol 2018;37:305)
- Tubular Krukenberg tumor (i.e. tubular variant of metastatic signet ring cell carcinoma):
- Endometrioid adenocarcinoma, especially sertoliform variant (Mod Pathol 1999;12:933):
- Retiform Sertoli-Leydig cell tumors:
- Yolk sac tumor:
- Lacks Leydig cell component
- Positive for AFP and SALL4 (Histopathology 2014;65:51)
- Low grade serous tumors (borderline tumor and low grade serous carcinoma):
- Positive for CK7
- Lacks Leydig cell component
- Often bilateral
- Yolk sac tumor:
- Sertoli-Leydig cell tumors with heterologous elements:
- Carcinosarcoma:
- Mucinous tumors (primary ovarian and metastatic):
- Lack of the surrounding atypical sex cord (Sertoli cell) and Leydig cell component
- Teratoma:
- Lack of atypical sex cord (Sertoli cell) and Leydig cell component
- Usually predominant ectodermal component
Board review style question #1
Board review style answer #1
B. DICER1. Somatic hotspot missense mutation affecting the RNase IIIb domain of DICER1 gene are common in Sertoli-Leydig cell tumors. In a recent large case series, all moderately and poorly differentiated Sertoli-Leydig cell tumors harbored DICER1 mutations.
Comment Here
Reference: Sertoli-Leydig cell tumor
Comment Here
Reference: Sertoli-Leydig cell tumor
Board review style question #2
Sertoli-Leydig cell tumors of the ovary typically show which of the following immunoprofiles?
- CK7+ / EMA+ / inhibin- / calretinin+
- CK7- / EMA+ / inhibin+ / calretinin-
- CK7- / EMA- / inhibin+ / calretinin+
- CK7- / EMA- / inhibin+ / calretinin-
Board review style answer #2
C. CK7- / EMA- / inhibin+ / calretinin+. Sertoli-Leydig cell tumors express general sex cord immunohistochemical markers, such as inhibin and calretinin. CK7 and EMA immunostains are negative and can help differentiate Sertoli-Leydig cell tumors from sertoliform endometrioid adenocarcinoma of the ovary, which is typically positive for both CK7 and EMA.
Comment Here
Reference: Sertoli-Leydig cell tumor
Comment Here
Reference: Sertoli-Leydig cell tumor